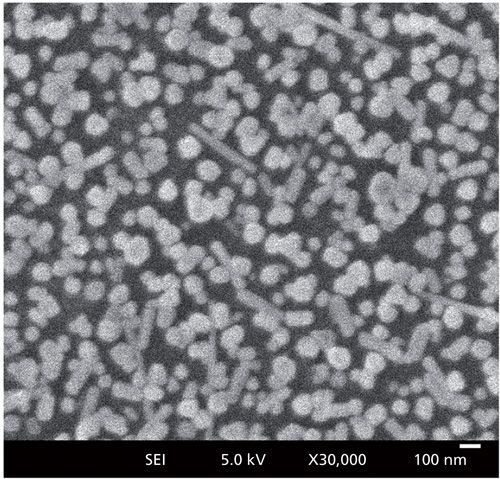
Wu-figure1_web.jpg

Spectroscopy
Infrared spectroscopy is an appealing technique for application to forensic samples because it offers the benefits of being non-destructive and non-hazardous, fast, reasonably sensitive, and resistant to some of the interferences of many commonly used techniques. Our research team has been focusing on detecting biological fluids on fabrics, which are inherently anisotropic substrates for spectroscopy. The work presented here investigates the effect of azimuthal angle of the sample on the infrared diffuse reflection spectra of fabrics with a goal of removing sampling differences as a source of analytic variation.